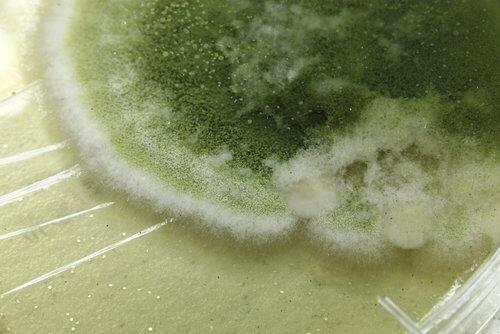
वॉशिंग मशीन की फफूँद

वॉशिंग मशीन की फफूँद को हटाने के लिए आज़माएँ यह नेचुरल साधन

आपकी वॉशिंग मशीन घर में सबसे ज्यादा इस्तेमाल किये जाने वाले साधनों में से है। लेकिन यह भी सही है कि यह उतना ही उपेक्षित उपकरण भी है। इसलिए वॉशिंग मशीन की फफूँद एक आम समस्या है।
करीब-करीब सभी लोग अपने घर में इसे इस्तेमाल करते हैं। वॉशिंग मशीन से फफूँद की सफ़ाई के लिए आप इस घरेलू सोल्यूशन का उपयोग कर सकते हैं। इसे दो हफ़्तों में एक बार लगायें और रबर के सील को अच्छी तरह से सुखाएं।
व्यस्त कारोबारी जीवन, घर की जिम्मेदारियां, बच्चों की देखभाल आदि में हमारा ज्यादा से ज्यादा वक्त निकल जाता है। ऐसे में वॉशिंग मशीन हमें अपना समय बचाने में मदद करती है।
हम अपनी वॉशिंग मशीन को बहुत ज्यादा इस्तेमाल करते हैं। इसलिए उसके पुरजों पर जोर पड़ता है। उसके रबर के सील पर अक्सर फफूँद जम जाती है।
फफूँद क्या होती है?

फफूँद एक प्रकार का कवक है। यह अँधेरे और नम वातावरण में पाई जाती है। ये अनेक प्रकार की होती हैं। अक्सर ये प्रत्यक्ष दिखाई नहीं देती हैं।
नम वातावरण के अलावा फफूँद एकदम सूखी जगहों में भी रह सकती है। लेकिन ऐसी जगहों पर उसकी प्रजनन प्रक्रिया संभव नहीं होती है।
यह आपकी वॉशिंग मशीन के अंदर फलती-फूलती और जमा होती है। एक अच्छी बात यह है कि यह आपके कपड़ों के रूप-रंग पर असर नहीं करती है।
हालांकि वॉशिंग मशीन के अंदर पड़े हुए कपड़ों पर फफूँद लग सकती है। उसके कारण कपड़ों में गंदी बदबू आ सकती है या उनमें संक्रमण हो सकता है।
वॉशिंग मशीन की फफूंद कैसे पैदा होती है?
अभी हमने देखा कि फफूंद क्या है। आइये देखें कि वह कैसे पनपती है। वॉशिंग मशीन में पानी और साबुन के कारण फफूंद उत्पन्न होती है।
मशीन में कवक को इन दोनों चीजों और अधिक नमी की वजह से बढ़ने के लिए एक उत्तम वातावरण मिल जाता है।
उसको पहचानना आसान होता है। वह अधिकतर गहरे हरे रंग की और घनी होती है।
वॉशिंग मशीन की फफूँद को हटाने का प्राकृतिक विकल्प
घर में सफाई करने के लिए अपने पास अनेक क्लीनिंग प्रोडक्ट रखने पड़ते हैं। यह सभी लोग जानते हैं कि उनमें तेज रसायन होते हैं। इसके अतिरिक्त वे काफी महंगे होते हैं।
उनका आपके जीवन पर कई तरह का नकारात्मक प्रभाव हो सकता है। उनके रसायनों के कारण शारीरिक बीमारियाँ हो सकती हैं। इसके अलावा वे वॉशिंग मशीन को नुकसान पहुंचा सकते हैं।
ऊँचे दामों के कारण उनका आपके बजट पर भी असर होता है। खुशी की बात यह है कि अनेक विकल्प उपलब्ध हैं जो वातावरण के लिए अच्छे और आर्थिक रूप से बेहतर हैं।
एक प्राकृतिक विकल्प
अगर आप अपने घर की सफाई करने के लिए भिन्न प्रकार के तरीके खोज रहे हैं तो प्राकृतिक विकल्पों को नज़रअंदाज़ न करें।
वे बाज़ार में बिकने वाले प्रोडक्ट से करीब-करीब हर तरह से बेहतर हैं। वे सस्ते, अधिक प्रभावशाली और स्वास्थ्य के लिए कम हानिकारक होते हैं।
अपनी वॉशिंग मशीन को अंदर और बाहर से साफ करने और फफूंद को पूरी तरह से हटाने के लिए इस पूर्ण प्राकृतिक विकल्प का उपयोग करें:
सामग्री
- 1/4 प्याला नींबू का रस
- 3 लीटर पानी
- 1 प्याला हाइड्रोजन पेरोक्साइड
- स्प्रे करने की बोतल
विधि और उपयोग

- एक बाल्टी में इन सभी चीजों को मिलाएं। उस घोल को एक स्प्रे करने की बोतल में डालें।
- अच्छी तरह हिलाएं। ध्यान रखें कि ढक्कन कस कर बंद होना चाहिए।
- हाथों में दस्ताने पहनें। मुंह को मास्क से ढंकें ताकि सांस के साथ फफूंद के स्पोर्स को आप कहीं अंदर न लें और बदबू से बचे रहें।
- जिन जगहों पर फफूंद लगी हुई है वहां स्प्रे करें।
- कुछ क्षणों के लिए उसे छोड़ दें और काम करने दें। फिर एक नम कपड़े से पोंछें।
- थोड़ा से घोल को मशीन में साबुन डालने की जगह पर उड़ेलें। वॉशिंग मशीन को गर्म पानी से धोने के लिए वॉशिंग साइकिल पर सेट करें ताकि वह अच्छी तरह साफ हो जाये।
वॉशिंग मशीन की फफूँद को पनपने से किस प्रकार रोकें?

संभव है, अप वॉशिंग मशीन की फफूँद को हटाने के लिए आप पहली बार उसे साफ कर रहे हों।
वास्तव में हमें यह प्रयत्न करना चाहिए कि फफूंद उत्पन्न ही न हो और हम गंदी बदबू और संक्रमण से बचे रहें।
वॉशिंग मशीन की फफूँद को पनपने से रोकने के लिए यहाँ कुछ युक्तियाँ बताई गयी हैं:
- वॉशिंग मशीन को इस्तेमाल करने के बाद उसके ढक्कन को खुला छोड़ दें।
- गीले कपड़ों को निकाल लें ताकि अंदर नमी न बढ़े।
- सील को सुखाएं।
- हमने इस लेख में जिस प्राकृतिक घोल को बनाने के बारे में बताया है उसे दो हफ़्तों में एक बार इस्तेमाल करें।
आपकी वॉशिंग मशीन घर में सबसे ज्यादा इस्तेमाल किये जाने वाले साधनों में से है। लेकिन यह भी सही है कि यह उतना ही उपेक्षित उपकरण भी है। इसलिए वॉशिंग मशीन की फफूँद एक आम समस्या है।
करीब-करीब सभी लोग अपने घर में इसे इस्तेमाल करते हैं। वॉशिंग मशीन से फफूँद की सफ़ाई के लिए आप इस घरेलू सोल्यूशन का उपयोग कर सकते हैं। इसे दो हफ़्तों में एक बार लगायें और रबर के सील को अच्छी तरह से सुखाएं।
व्यस्त कारोबारी जीवन, घर की जिम्मेदारियां, बच्चों की देखभाल आदि में हमारा ज्यादा से ज्यादा वक्त निकल जाता है। ऐसे में वॉशिंग मशीन हमें अपना समय बचाने में मदद करती है।
हम अपनी वॉशिंग मशीन को बहुत ज्यादा इस्तेमाल करते हैं। इसलिए उसके पुरजों पर जोर पड़ता है। उसके रबर के सील पर अक्सर फफूँद जम जाती है।
फफूँद क्या होती है?
फफूँद एक प्रकार का कवक है। यह अँधेरे और नम वातावरण में पाई जाती है। ये अनेक प्रकार की होती हैं। अक्सर ये प्रत्यक्ष दिखाई नहीं देती हैं।
नम वातावरण के अलावा फफूँद एकदम सूखी जगहों में भी रह सकती है। लेकिन ऐसी जगहों पर उसकी प्रजनन प्रक्रिया संभव नहीं होती है।
यह आपकी वॉशिंग मशीन के अंदर फलती-फूलती और जमा होती है। एक अच्छी बात यह है कि यह आपके कपड़ों के रूप-रंग पर असर नहीं करती है।
हालांकि वॉशिंग मशीन के अंदर पड़े हुए कपड़ों पर फफूँद लग सकती है। उसके कारण कपड़ों में गंदी बदबू आ सकती है या उनमें संक्रमण हो सकता है।
वॉशिंग मशीन की फफूंद कैसे पैदा होती है?
अभी हमने देखा कि फफूंद क्या है। आइये देखें कि वह कैसे पनपती है। वॉशिंग मशीन में पानी और साबुन के कारण फफूंद उत्पन्न होती है।
मशीन में कवक को इन दोनों चीजों और अधिक नमी की वजह से बढ़ने के लिए एक उत्तम वातावरण मिल जाता है।
उसको पहचानना आसान होता है। वह अधिकतर गहरे हरे रंग की और घनी होती है।
वॉशिंग मशीन की फफूँद को हटाने का प्राकृतिक विकल्प
घर में सफाई करने के लिए अपने पास अनेक क्लीनिंग प्रोडक्ट रखने पड़ते हैं। यह सभी लोग जानते हैं कि उनमें तेज रसायन होते हैं। इसके अतिरिक्त वे काफी महंगे होते हैं।
उनका आपके जीवन पर कई तरह का नकारात्मक प्रभाव हो सकता है। उनके रसायनों के कारण शारीरिक बीमारियाँ हो सकती हैं। इसके अलावा वे वॉशिंग मशीन को नुकसान पहुंचा सकते हैं।
ऊँचे दामों के कारण उनका आपके बजट पर भी असर होता है। खुशी की बात यह है कि अनेक विकल्प उपलब्ध हैं जो वातावरण के लिए अच्छे और आर्थिक रूप से बेहतर हैं।
एक प्राकृतिक विकल्प
अगर आप अपने घर की सफाई करने के लिए भिन्न प्रकार के तरीके खोज रहे हैं तो प्राकृतिक विकल्पों को नज़रअंदाज़ न करें।
वे बाज़ार में बिकने वाले प्रोडक्ट से करीब-करीब हर तरह से बेहतर हैं। वे सस्ते, अधिक प्रभावशाली और स्वास्थ्य के लिए कम हानिकारक होते हैं।
अपनी वॉशिंग मशीन को अंदर और बाहर से साफ करने और फफूंद को पूरी तरह से हटाने के लिए इस पूर्ण प्राकृतिक विकल्प का उपयोग करें:
सामग्री
- 1/4 प्याला नींबू का रस
- 3 लीटर पानी
- 1 प्याला हाइड्रोजन पेरोक्साइड
- स्प्रे करने की बोतल
विधि और उपयोग

- एक बाल्टी में इन सभी चीजों को मिलाएं। उस घोल को एक स्प्रे करने की बोतल में डालें।
- अच्छी तरह हिलाएं। ध्यान रखें कि ढक्कन कस कर बंद होना चाहिए।
- हाथों में दस्ताने पहनें। मुंह को मास्क से ढंकें ताकि सांस के साथ फफूंद के स्पोर्स को आप कहीं अंदर न लें और बदबू से बचे रहें।
- जिन जगहों पर फफूंद लगी हुई है वहां स्प्रे करें।
- कुछ क्षणों के लिए उसे छोड़ दें और काम करने दें। फिर एक नम कपड़े से पोंछें।
- थोड़ा से घोल को मशीन में साबुन डालने की जगह पर उड़ेलें। वॉशिंग मशीन को गर्म पानी से धोने के लिए वॉशिंग साइकिल पर सेट करें ताकि वह अच्छी तरह साफ हो जाये।
वॉशिंग मशीन की फफूँद को पनपने से किस प्रकार रोकें?

संभव है, अप वॉशिंग मशीन की फफूँद को हटाने के लिए आप पहली बार उसे साफ कर रहे हों।
वास्तव में हमें यह प्रयत्न करना चाहिए कि फफूंद उत्पन्न ही न हो और हम गंदी बदबू और संक्रमण से बचे रहें।
वॉशिंग मशीन की फफूँद को पनपने से रोकने के लिए यहाँ कुछ युक्तियाँ बताई गयी हैं:
- वॉशिंग मशीन को इस्तेमाल करने के बाद उसके ढक्कन को खुला छोड़ दें।
- गीले कपड़ों को निकाल लें ताकि अंदर नमी न बढ़े।
- सील को सुखाएं।
- हमने इस लेख में जिस प्राकृतिक घोल को बनाने के बारे में बताया है उसे दो हफ़्तों में एक बार इस्तेमाल करें।
- Melikyan, A. V., & Stewart, P. H. (1997). U.S. Patent No. 5,602,090. Washington, DC: U.S. Patent and Trademark Office.
यह पाठ केवल सूचनात्मक उद्देश्यों के लिए प्रदान किया जाता है और किसी पेशेवर के साथ परामर्श की जगह नहीं लेता है। संदेह होने पर, अपने विशेषज्ञ से परामर्श करें।







